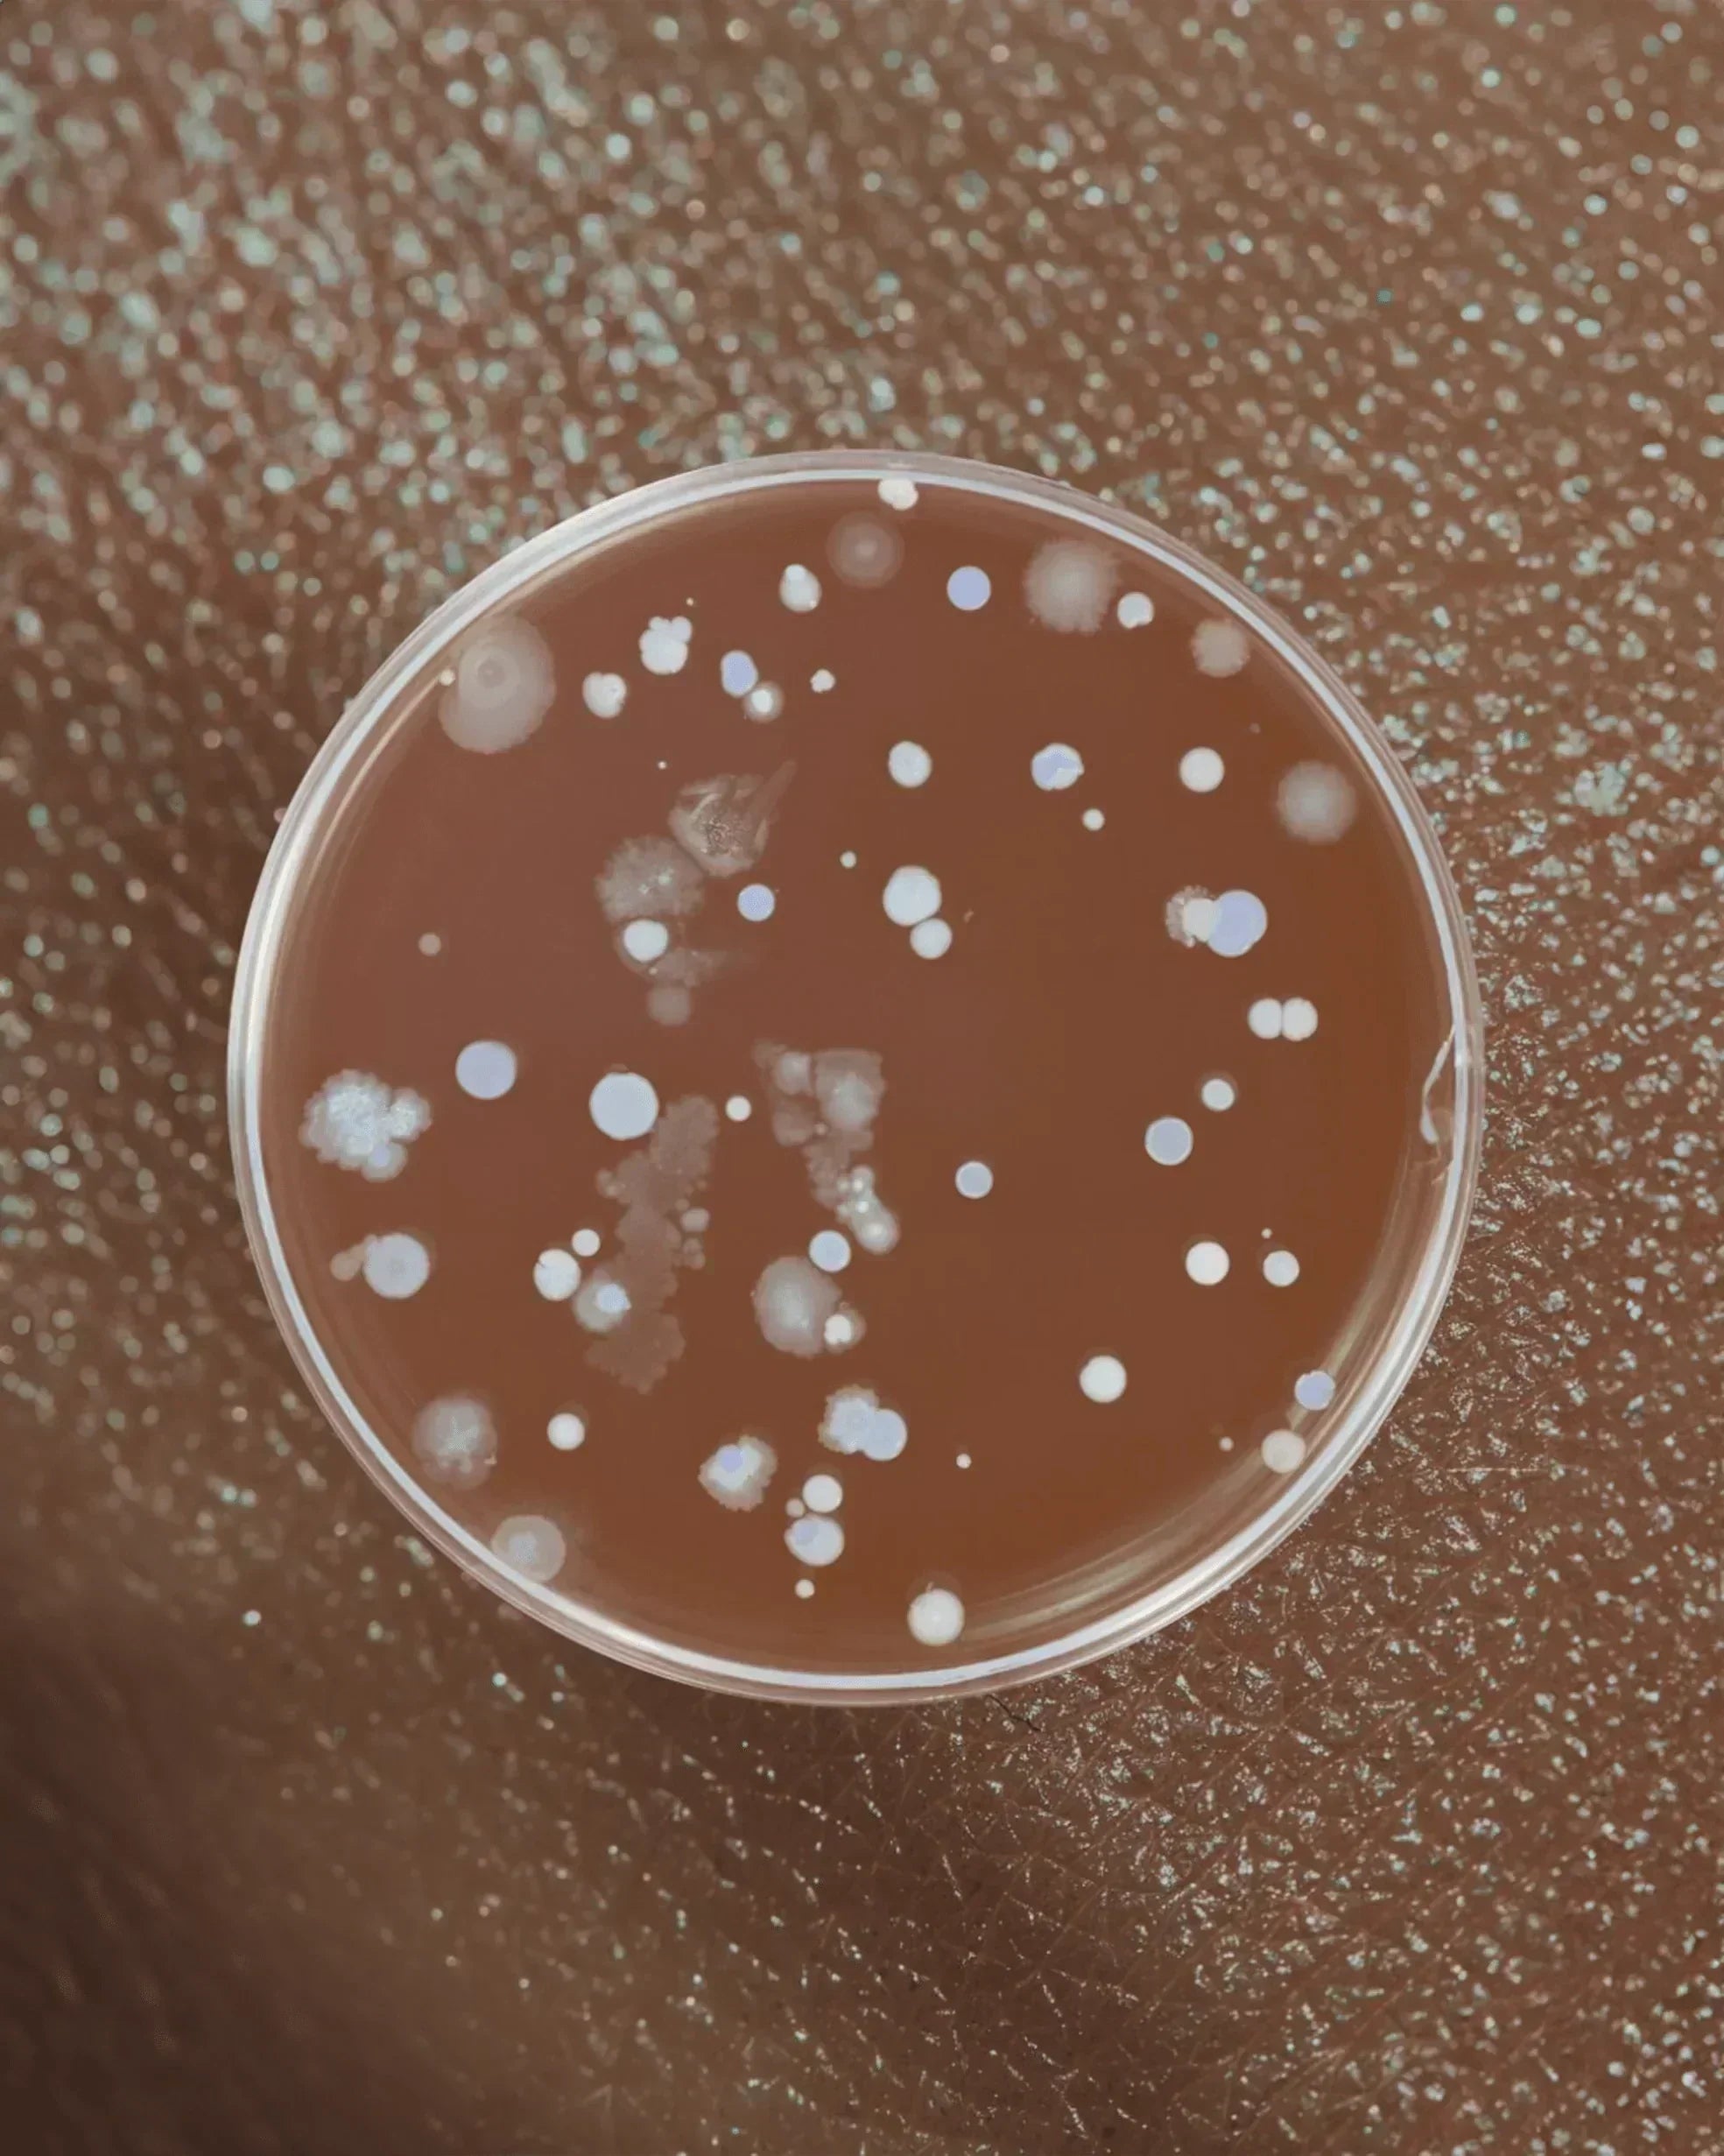
Vaginal Ecology 101: How to Keep Your Microbiome Healthy (And Why It Matters for UTIs) - GOODKITTYCO

quick UTI checklist
Do you have a urinary tract infection? If it burns when you pee, you probably already know the answer. Here's how to be sure and what to do about it.
UTI symptoms
UTI symptoms
the standard edition
✔️ Burning when you pee (the #1 telltale sign)
✔️ Constant urge to pee (but barely anything comes out)
✔️ Urgency that feels like an emergency
✔️ Strong-smelling or cloudy urine
✔️ Pelvic pressure or lower belly pain
✔️ Blood in your urine (pink, red, or brownish)
If you checked 2 or more boxes: You likely have a UTI. Time to see a doctor.
WARNING SIGNS:
WARNING SIGNS:
These symptoms suggest your UTI has spread to your kidneys:
⚠️ Fever or chills
⚠️ Severe back, side, or groin pain
⚠️ Nausea or vomiting
⚠️ Dark or bloody urine
Kidney infections require immediate treatment. Don't wait.
call your doctor now.
UTIs need antibiotics.
what to do now
what to do right now
1. See a Doctor - What to ask for:
- Urinalysis (quick bacteria check)
- Urine culture (identifies which bacteria so you get the right antibiotic)
2. Take Your Antibiotics Correctly
Finish the entire course—even if you feel better in 2 days.
3. Support Your Recovery
- Drink lots of water
- Pee often (don't hold it)
- Use a heating pad for discomfort
- Take a probiotic (2+ hours apart from antibiotic)
- Avoid alcohol, caffeine, and spicy foods
UTI Prevention
Prevent Your Next UTI
Once you've had one, you're at higher risk for another. Here's how to break the cycle:
Daily Defense: Take UTI Biome Shield daily
→ 100% bioavailable cranberry PACs (36mg) + D-mannose + vitamin D3 + zinc: Prevents bacteria from sticking to your bladder walls
Smart Habits:
- Pee after sex
- Stay hydrated (8-12 glasses daily)
- Wipe front to back
- Don't hold your pee
- Avoid douches, scented products, and spermicides
For Menopause/Postpartum: Ask your doctor about vaginal estrogen → Reduces recurrent UTI risk by 50-60%
ALARMING FACTS
70% of UTI-causing bacteria evade multiple antibiotics
30% multi-drug resistant
UTIs are the #2 cause of antibiotic prescriptions
60% of recurrent UTI patients are put on long-term prophylactic antibiotics
Our revolutionary UTI BIOME SHIELD is medical-grade formula is active in 30 minutes and creates a 12-hour bacterial shield—without triggering resistance.


Certain risk factors based on age, sexual activity, and medical history can increase the chance of UTIs.
Half of all women experience a UTI, and 1 in 10 have three or more a year.
Sex causes 85% of UTIs. Bacteria can enter the urethra during intercourse.
Menopause can cause a UTI. Reduced estrogen changes can impact the urinary tract and vagina, also known as genitourinary syndrome of menopause (GSM), making them more vulnerable to infection.
Hormonal shifts during and after pregnancy can cause a UTI. Anatomical pelvic floor and hormonal changes can increase susceptibility to bacterial infections.
Contraception can cause a UTI. Diaphragms and some spermicidal agents may increase the risk.
Kidney stones (or an enlarged prostate) or any other urinary tract blockage can prevent the bladder from flushing out harmful bacteria.
Diabetes and other conditions that may slow or stop the body from fighting infection increases risk.
Using catheters to urinate – for instance, when hospitalized, paralyzed, or dealing with neurological problems – may lead to UTIs.
UTI education

Recurrent UTIs are incredibly common, especially in women. Understanding your bladder microbiome and what disrupts it is the first step toward taking control of your urinary health.

Condoms don’t cause UTIs, but some can make you more vulnerable—especially if you’re already prone to infections. From spermicides to fragrances to friction, here’s what actually increases UTI risk...

Hell hath no fury like a woman who comes down with a UTI after (let's face it, probably pretty mediocre) sex.

Spoiler: If it burns when you pee, you probably already know the answer.

Low estrogen is a hidden driver of recurrent UTIs—and vaginal estrogen might be the solution you didn't know existed. For the most comprehensive protection, combine vaginal estrogen with Good Kitty...

Gamechanger in UTI Prevention survival guide: The right way to pee after sex—make it a real flush.

Standard cranberry supplements have 0-5% bioavailability. That means your body absorbs almost nothing. Here's why you're flushing $20 a month down the toilet and what actually works.

Let's talk about the thing your doctor might suggest when you're on your fifth UTI of the year and both of you are exhausted: prophylactic antibiotics. Translation: taking a low-dose antibiotic eve...

Why It Happens & How to Prevent It Naturally Discover why sex triggers UTIs in women, the 5-step infection process, and 7 natural prevention strategies including Good Kitty UTI Biome Shield's m...

Learn to distinguish between UTI and overactive bladder symptoms, causes, and treatments. Stop misdiagnosis and find the right solution for your frequent urination.
uti questions & answers
Featured UTI Questions
A UTI is a bacterial infection in any part of the urinary system, which can include the kidneys, ureters, bladder, and urethra. The most effective treatment for a UTI is an antibiotic. UTI's can be quite uncomfortable and the ability to get a same-day doctor appointment for prescription medication can be challenging.
Yes, UTIs are very common, especially for women. UTIs are the second most common type of infection in the body. About 10 in 25 women and 3 in 25 men will have symptoms in their lifetime.
A UTI is quite painful, and it's easy to recognize the signs, which can include one or all of the following:
- Urine that has a strong or foul order
- An increased urgency to urinate, yet a small amount comes out
- A burning sensation when you urinate
- Urine that appears cloudy
- Possible blood in the urine
- Fever and/or chills
- Body aches
- Nausea
- Suprapubic pain or pressure
If you are exhibiting any of these symptoms and think you may have a UTI, call your doctor or go to an Urgent Care.
Yes, the most effective treatment for a UTI is a prescription antibiotic from a medical professional, which is not available over the counter. If you are experiencing signs of a UTI, a U.S.-licensed provider can prescribe antibiotics and send them to your local pharmacy.
You can buy over-the-counter UTI dipstick tests at your local pharmacy or online. They work much like a pregnancy test: Each kit comes with a testing strip (usually three to a kit). You wet a test strip by holding it in your pee stream for a few seconds
A urinary tract infection (UTI) can sometimes go away on its own, but it is not guaranteed, and it is best to see a doctor because untreated UTIs can lead to serious complications like kidney infections or even sepsis. Antibiotics are the standard treatment for most UTIs and can quickly relieve symptoms. If you have symptoms of a UTI, such as burning with urination, increased urgency to urinate, or lower abdominal pain, you should contact a healthcare provider for advice and treatment.
The answer depends on your specific UTI symptoms and health history. Certain antibiotics are recommended for simple versus complicated UTIs that may have underlying factors contributing to the origin of the infection. Your assigned medical provider will determine if you are a candidate for UTI treatment and, if so, what antibiotics make sense for you. If you require complicated UTI treatment, your provider may suggest you visit your local doctor's office or clinic.
If you are searching for how to get rid of a UTI, an antibiotic is the best option for treatment, and it is not available over the counter. The medications we offer work by killing the bacteria that cause the UTI.
Only a U.S.-licensed healthcare provider will closely evaluate your medical history and current symptoms to determine if you are a good candidate for antibiotics.

UTI vs OAB
Learn to distinguish between UTI and overactive bladder symptoms, causes, and treatments. Stop misdiagnosis and find the right solution for your frequent urination.

the UTI you can't shake
Chronic vs. Recurrent Infections: Burning keeps coming back after antibiotics? Learn the difference between recurrent and chronic UTIs, how biofilms cause persistent infections, and what actually helps.
pelvic health

Three-quarters of women will experience a vaginal yeast infection at some point in their lives. Yet we still treat them like shameful secrets rather than common fungal imbalances with identifiable ...

BV, yeast infections, and cytolytic vaginosis can look and feel confusingly similar—but they’re caused by completely different microbial imbalances. This guide breaks down what each one is, how to ...

We're exceptional at ignoring our own bodies until symptoms become impossible to dismiss. But what if that persistent exhaustion, those recurring headaches, or that burning sensation when you pee i...

Recurrent UTIs aren't a personal failing or a hygiene issue—they're your body's ecosystem sending an SOS. Understanding the gut-vagina-bladder connection is the first step to breaking the cycle of ...

Recurrent UTIs are often caused by biofilm—bacteria shielded from antibiotics. Learn why UTIs return and how to prevent chronic bladder infections.

BV and UTIs often get confused, but they’re completely different infections that need completely different treatments. Here’s how to spot the symptoms, avoid misdiagnosis, and protect your vaginal ...

BV and yeast infections can flare after antibiotics, sex, or even the wrong lubricant. Here’s what actually causes imbalance—and how gentle, science-backed support like UTI Biome Shield can help ke...
Your vagina is a living ecosystem. Learn how your vaginal microbiome affects UTIs, BV, fertility, immunity, and overall health—and how to keep it in balance.

Your period is more than a monthly inconvenience—it’s a vital sign. Learn what your cycle reveals about hormones, thyroid health, stress, and overall wellbeing.

Here's a fun fact nobody tells you: the period products marketed as "natural," "organic," and "non-toxic" might be poisoning you.
more uti questions & answers
Additional UTI Questions
Yes, this is very common.
Not directly, but they can help reduce bacteria transfer.
UTI Biome Shield Clinically proven UTI prevention in one revolutionary purple pill.
Multi-action defense system powered by our exclusive PACphenol™ and BioBlocD3™, engineered to stop UTIs before they start. Unlike antibiotics that disrupt your microbiome, our physician-developed formula supports beneficial bacteria, neutralizes E. coli introduced during intimate moments, and addresses the gut reservoir of UTI-causing bacteria, one of the main root causes of recurrence.
DETAILS: Our clinically proven formula combines PACphenol™ (38mg soluble PACs and polyphenols) with BioBlocD3™ (d-mannose complexed with vitamin D3 and zinc) for complete UTI defense. Our formula doesn't just fight bacteria—prebiotics restore your microbiome's natural balance, bioactives heal damaged bladder tissue and strengthen your immune response.
- BLOCK E. coli receptor sites
- ELIMINATE biofilm
- REPAIR bladder tissue
- OPTIMZE microbiome
UTI Biome Shield Clinically proven UTI prevention in one revolutionary purple pill.
Multi-action defense system powered by our exclusive PACphenol™ and BioBlocD3™, engineered to stop UTIs before they start. Unlike antibiotics that disrupt your microbiome, our physician-developed formula supports beneficial bacteria, neutralizes E. coli introduced during intimate moments, and addresses the gut reservoir of UTI-causing bacteria, one of the main root causes of recurrence.
DETAILS: Our clinically proven formula combines PACphenol™ (38mg soluble PACs and polyphenols) with BioBlocD3™ (d-mannose complexed with vitamin D3 and zinc) for complete UTI defense. Our formula doesn't just fight bacteria—prebiotics restore your microbiome's natural balance, bioactives heal damaged bladder tissue and strengthen your immune response.
- BLOCK E. coli receptor sites
- ELIMINATE biofilm
- REPAIR bladder tissue
- OPTIMZE microbiome
Friction during intercourse can push bacteria into the urethra. This is especially common in women due to anatomy.
No, UTIs are not contagious.
Your period is not likely to cause a UTI. However, hygiene is essential, including regularly changing your menstrual pads and tampons and adequately washing your menstrual cups to avoid introducing bacteria near the urethra.
Urologist Approved. Physician Formulated.
Scientifically proven to prevent UTIs. Powered by PACphenol™ and BioBlocD3™, our multi-action defense system stops problems before they start by blocking E. coli, supporting bladder wall repair, disrupting biofilm, and supporting a balanced microbiome.
Each Kit incudes:
- UTI Biome Shield 60 Capsules
- FREE: Exclusive refillable brass canister
- FREE: 24k gold-plated pill-stash pendant
Unlike antibiotics, our science backed formula works with your body. Each daily dose delivers 37mg soluble cranberry PACs, polyphenols, d-mannose, vitamin D3, and zinc for complete, bioholistic protection.
Designed for real life:
- BLOCK e.coli receptor sites
- ELIMINATE biofilm
- REPAIR bladder tissue
- SUPPORT healthy microbiome
- BOOST natural immunity


